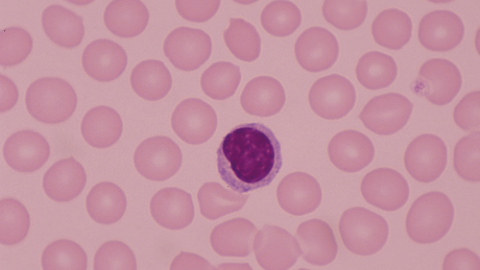

新华网天津11月1日电(记者 宫晓倩)“急性髓系白血病是常见的白血病之一,其病程短且预后凶险,如不及时治疗常可危及生命。”近日,中国医学科学院血液病医院(中国医学科学院血液学研究所)白血病诊疗中心主任医师魏辉教授在接受新华网采访时表示,急性髓系白血病发病症状多样,很容易被忽视,如果出现牙龈肿、贫血、容易疲惫、发烧、皮肤有出血点等症状需要警惕,建议及时到医院检查,一旦确诊,尽早进行治疗。
急性髓系白血病病症多样 主要归纳为四大方面
据悉,急性髓系白血病是一种造血系统细胞异常增殖导致的恶性肿瘤,属于急性白血病的范畴。白血病总体发病率是约10万分之3,其中急性白血病占很大一部分。
“急性髓系白血病发病症状多样,可以归纳为四大方面。”魏辉表示,首先是侵袭性症状,例如牙龈肿、淋巴肿、皮肤侵袭,在消化道、生殖系统甚至脑部等其他各个器官形成结节、肿瘤等。其他三方面与血常规有关,如果红细胞有问题,会出现贫血、身体疲惫、脸色发白等;血小板有问题,轻的症状是皮肤有出血点,身体容易青一块紫一块、牙龈出血、鼻子出血,重的话会出现脏器出血;白细胞出现问题,那患者抗感染能力下降,容易引起消化道、呼吸道等的感染,出现发烧等症状。
魏辉介绍,从门诊来看,老年患者的比例在增加。一是随着国家老龄化趋势加重,老年人口增加,患病人数也在增加。二是随着经济条件的改善、人们认知水平的提高,一些老年患者也更愿意到医院接受正规的治疗。
魏辉指出,急性髓系白血病的发病原因尚不明确,但可以明确一些因素可能会产生影响:一是外在因素,例如接触放射线、接触苯类化学制剂、病毒因素等;二是内在因素,例如家族遗传基因异常、对疾病的易感性等。
急性髓系白血病发病凶猛 多种治疗方法提高治愈率
据了解,按照病程长短、疾病分化程度,白血病可分为急性白血病和慢性白血病。魏辉表示,目前治疗慢性白血病的药物有很多,它本身病程很长,有的可以长达十几年,可视为慢性病。相比于慢性白血病,急性白血病危害很大,一般发病特别凶猛,尤其是急性髓系白血病,它预后凶险,严重威胁着人们的生命健康。
不过,魏辉也表示,有些急性髓系白血病是可以治愈的,这部分主要集中在60岁以下的患者群体。而对于60岁以上,尤其是70岁以上的患者,临床上更多的采用姑息治疗,以提高生存质量、延长生存期为目的。
目前,临床上,急性髓系白血病治疗手段主要包括化疗、骨髓移植或者干细胞移植、靶向治疗等。魏辉介绍,化疗和移植是早期的治疗方法,使用的时间非常久远,治疗的患者数量也最多,很多患者经过了化疗和移植达到了治愈的目标。而随着医学的不断发展,靶向治疗成为急性髓系白血病患者的新选择,靶向治疗可以分成两方面,一个是小分子靶向治疗,例如针对特定靶点的BCL-2抑制剂、FLT3抑制剂等,另一个是免疫治疗,例如目前比较热门的CAR-T治疗等。临床上,常常将靶向治疗与移植、化疗相结合,综合治疗以达到提高治愈率的目的。
据悉,在急性髓系白血病患者中最常见的基因突变是FLT3基因突变,带有FLT3基因突变的患者非常容易复发。“FLT3突变患者一旦复发,按照常规的化疗手段,缓解的可能性就很低了,这时候临床上更多地会借助于FLT3抑制剂这一类靶向药物,多种方法进行组合以提高疗效。”魏辉表示。
近年来,针对急性髓系白血病突变基因的研究不断取得突破性进展,越来越多的靶向药物被开发出来。“有的放矢的特异性、靶向性治疗,也正式使急性髓系白血病治疗进入个体化治疗时代。”魏辉说。